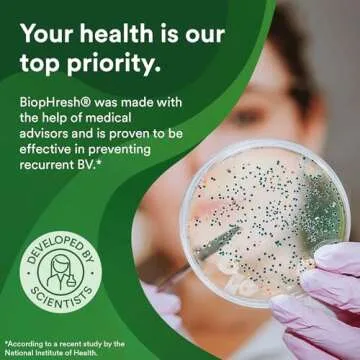
Good Clean Love BiopHresh Homeopathic Vaginal Suppository, Bacterial Vaginosis Treatment for Women, Relieves Itching & Irritation, Feminine Care, Promotes Urinary Tract & Vaginal Health, 10 Capsules

Good Clean Love BiopHresh Homeopathic Vaginal Suppository, Bacterial Vaginosis Treatment for Women, Relieves Itching & Irritation, Feminine Care, Promotes Urinary Tract & Vaginal Health, 10 Capsules
G
Good Clean Love
- 70
- 0
- 100+ Sold in the past week
- 💥 300+ people added this to wishlists
- ⏳ Hurry — stock running out!
- ⭐️ Trusted by shoppers









































































































































































































































































































































































































































































































































































































 Continue with Google
Continue with Google